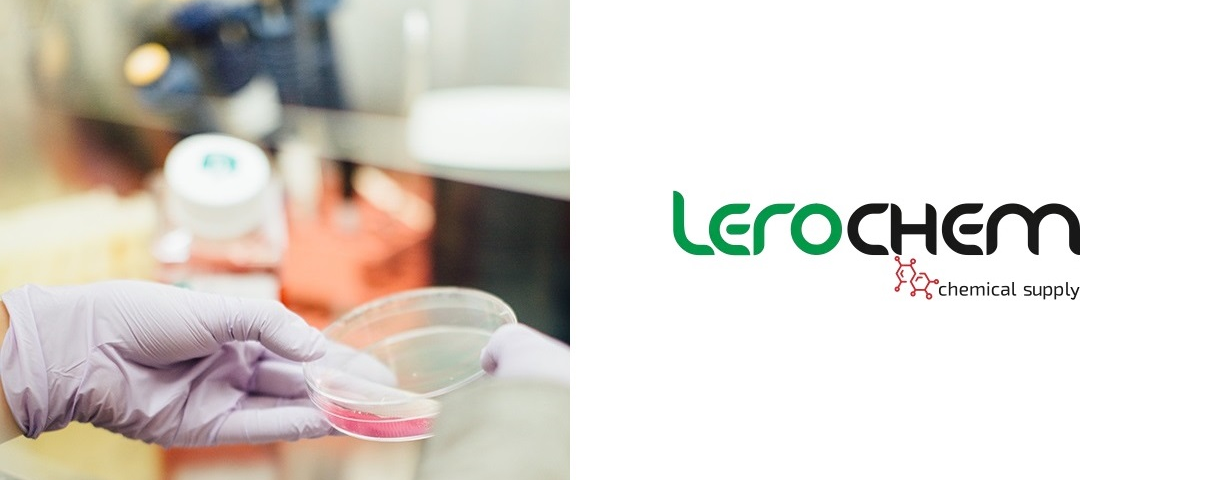

Lerochem, ein etablierter Anbieter spezialisierter chemischer Produkte, gibt die Erweiterung seines Produktportfolios sowie seine fortgesetzte Expansion im europäischen Markt bekannt. Das Unternehmen wurde kürzlich als A-Class Leader in seiner Branche ausgezeichnet und erhielt zudem den renommierten European Business Masters Award – eine Anerkennung für Qualität, Innovationskraft und konsequente Kundenorientierung.
Mit klarem Fokus auf den EU-Markt positioniert sich Lerochem durch eine besondere Kombination aus Produktvielfalt und Bestell-Flexibilität. Kunden haben die Möglichkeit, Stoffe nach Klassifikation ebenso wie Stoffe nach Verwendung zu beziehen – sowohl in größeren Volumina als auch in kleineren Mengen für Versuche, Tests oder Pilotproduktionen. Dieser Ansatz ist insbesondere für Unternehmen attraktiv, die neue Formulierungen evaluieren möchten, ohne auf gleichbleibende Qualität und Liefersicherheit zu verzichten.
Um Entwicklungsabteilungen und mittelständische Hersteller gezielt zu unterstützen, bietet Lerochem schnelle Angebotserstellung, transparente Lieferzeiten sowie Muster- und Labormengen an. Das Sortiment umfasst leistungsfähige Additive, Zwischenprodukte und spezialisierte Rohstoffe, unter anderem für die Kosmetikherstellung, die Wasseraufbereitung, Kunststoff – und Beschichtung Anwendungen sowie die Metallverarbeitung. Auch Salze gehören zu den regelmäßig nachgefragten Produktgruppen.
Der Unternehmenssitz in Klaipda ermöglicht dank direkter Hafennähe und eines EU-weiten Logistiknetzwerks eine effiziente und kostengünstige Belieferung internationaler Kunden. Sämtliche Produkte entsprechen den geltenden REACH – und CLP-Vorgaben. Kunden erhalten auf Wunsch chargenbezogene Dokumentation, Sicherheitsdatenblätter sowie technische Beratung.
„Diese Auszeichnungen bestätigen unseren langfristigen Anspruch, europäische Unternehmen zuverlässige und innovative chemische Lösungen bereitzustellen“, erklärt die Geschäftsführung von Lerochem. „Unser Ziel ist es, sowohl Entwicklungsprozesse als auch Serienproduktionen flexibel zu unterstützen – unabhängig von der Bestellgröße.“
Mit den jüngsten Anerkennungen baut Lerochem seine Marktposition weiter aus und plant, seine Aktivitäten innerhalb Europas gezielt zu erweitern. Dabei bleibt der Fokus klar auf nachhaltigem Wachstum, technischer Kompetenz und langfristigem Kundenerfolg.
Stoffe nach Klassifikation: https://lerochem.eu/de/54-stoffe-nach-klassifikation
Stoffe nach Verwendung: https://lerochem.eu/de/55-stoffe-nach-verwendung
Für die Kosmetikherstellung: https://lerochem.eu/de/71-fuer-die-kosmetikherstellung
Weitere Stoffe-Einsatzmöglichkeiten auf der Lerochem-Webseite.
Über Lerochem:
Lerochem ist ein vertrauenswürdiger europäischer Chemikalienlieferant und bietet ein breites Portfolio an Stoffen nach Klassifikation und Stoffen nach Verwendung. Das Unternehmen ist bekannt für seine spezialisierte Produktauswahl, flexible Liefermodelle und beratungsorientierten Vertrieb. Als A-Class Leader ausgezeichnet und Träger des European Business Masters Award unterstützt Lerochem Unternehmen bei der Entwicklung, Skalierung und Optimierung ihrer Produktionsprozesse.
Ein beratender Vertriebsansatz verbindet technische Spezialisten mit Einkaufsteams, um geeignete Alternativen vorzuschlagen, Rezepturen zu optimieren und die Gesamtkosten im Einsatz zu senken. Für Bestandskunden hält Lerochem Sicherheitsbestände vor, um Just-in-Time-Lieferungen zu ermöglichen und Versorgungssicherheit auch in volatilen Marktphasen zu gewährleisten.
Kontakt
UAB Lerochemas
Presse Team
Silutes pl. 105B
95145 Klaipeda
–

https://lerochem.eu/de/
Die Bildrechte liegen bei dem Verfasser der Mitteilung.